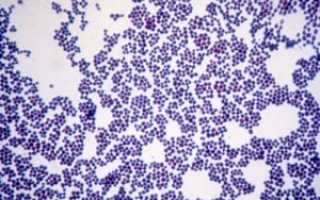
Кокки в мазке

Кокки в мазке – признак различных нарушений микрофлоры половых органов

Бактериоскопия – самый распространённый гинекологический анализ. Женщины и девушки разного возраста при прохождении профосмотра обязательно подвергаются такой процедуре. У 50-60% из них в мазке на флору обнаруживаются кокки. У мужчин они встречаются гораздо реже. Это связано с особенностями строения женской половой системы. Также кокки могут быть выявлены в мазке у ребёнка.
Бактерии при определённых обстоятельствах способны спровоцировать серьёзные заболевания мочеполовых и других органов, поэтому целесообразно узнать, что они собой представляют, когда угрожают здоровью и как с ними бороться.
Что такое кокки
В человеческом организме присутствует множество разных микробов. Кокки – семейство одноклеточных, названное от слова coccus, что в переводе с латыни означает – «шаровидный», а с древнегреческого – «зерно».
Как и другие бактерии, кокки обладают уникальной способностью к интенсивному размножению (примерно каждые полчаса). В благоприятных условиях одноклеточные делятся надвое, т.е. дробятся, из-за чего их ещё именуют «дробянками», а далее либо существуют по отдельности, либо объединяются в группы.
Кокки неподвижны, не образуют споры и являются анаэробными (могут обитать в безвоздушной среде).
Нормальная микрофлора
Здоровая микрофлора женских половых органов состоит из лактобактерий – палочек Дедерлейна, бифидобактерий и незначительного (около 5%) количества кокков. За счёт этого обеспечивается нормальное течение таких процессов, как:
- обмен веществ;
- регуляция уровня кислотности;
- уничтожение болезнетворных микробов.
Само по себе присутствие кокков в мазке у женщин неопасно и естественно. Когда баланс микроорганизмов поддерживается на должном уровне, в кислой среде полезные лактобактерии размножаются и создают защиту от грибков (молочницы), кишечной палочки и других вредных микробов. Соответственно, мочеполовая система функционирует стабильно и полноценно.
О чём говорят кокки в мазке
При нарушении микроклимата картина меняется: содержание кокков увеличивается, а полезные бактерии гибнут, поэтому если количество кокков в мазке превышает норму, это говорит о проблемах со здоровьем.
Норма: рН (уровень кислотности) – до 5. Слабокислая среда (начало воспалительного процесса): рН – до 7. Повышенная щелочная среда (активно развивается инфекция или воспаление): рН – более 7,5.
Для определения конкретного заболевания необходимо установить, какая именно разновидность шаровидных бактерий присутствует в избытке, а также выяснить наличие грамотрицательных и грамположительных кокков в мазке.
Эти термины появились благодаря датскому учёному Граму и его методу выявления устойчивых к медикаментам кокков. Дело в том, что многие бактерии имеют очень прочную оболочку, непроницаемую для большинства обычных антибиотиков (грамотрицательные).
Но и те микроорганизмы, чья клеточная стенка разрушается под воздействием антибактериальных препаратов (грамположительные), тоже способны вызывать серьёзные патологии, поскольку в результате продуктов их распада происходит интоксикация организма.
Только благодаря крепкому иммунитету и соблюдению всех правил лечения норма бактерий восстанавливается.
На вопрос: «Что значат кокки в мазке у женщины?» можно ответить так: дисбактериоз влагалища, снижение защитных функций лактобактерий и повышенная вероятность воспалительных процессов. Кокки в мазке у мужчин также указывают на нарушение работы мочеполовой системы.
Внимание! Такое состояние требует квалифицированной медицинской помощи. Народные методы, самостоятельный приём антибиотиков и других лекарств крайне нежелательны и могут лишь усугубить ситуацию.
Разновидности кокков
Выделяют несколько разновидностей бактерий, многие из которых являются условно-патогенными:
- Диплококки (известно более 80 видов). Существуют парами, бывают грамотрицательными и грамположительными. К наиболее патогенному типу относится гонококк – возбудитель гонореи. Заболевание стоит на первом месте по распространённости в числе ИППП (инфекций, передающихся половым путём).
- Стрептококки – микробы, соединённые в цепочку. Внешне кокки в мазке выглядят, как палочки, образованные из нескольких шароподобных клеток. На сегодняшний день открыто более 100 типов стрептококков (все грамположительные). Размножаясь в половых органах, они вызывают вагинит (воспаление влагалища), цистит (воспаление мочевого пузыря), цервицит (воспаление шейки матки), эндометрит (воспаление слизистой матки) и прочие патологии.
- Стафилококки (грамположительные). Представляют собой скопления, похожие на грозди винограда. Насчитывается 27 видов возбудителей, наиболее опасный – золотистый стафилококк. Присутствие большого количества стафилококков во влагалище способствует активному размножению других болезнетворных микробов, например грибков кандида (молочница). На фоне этого нередко воспаляются слизистая и придатки матки.
- Энтерококки (кокки овальной формы, располагающиеся цепочками или парами) – условно-патогенные представители кишечной микрофлоры, которые при недостаточности гигиены способны стремительно развиваться в мочеполовой системе.
- Коккобациллы (промежуточная между бациллами и кокками форма). Гемофильная палочка, гарднерелла, хламидии обнаруживаются при наличии венерических заболеваний, бактериального вагиноза.
- Гонококки. Имеют грамотрицательную структуру и овальную форму. При поражении мочеполового тракта вызывают воспалительную реакцию с последующим развитием цервицита и сальпингита.
Причины
Факторов, провоцирующих патологию, огромное множество. Основные причины кокков в мазке:
- Неграмотное лечение. В том случае, если человек принимает антибактериальные препараты без назначения или не соблюдает дозировку, вероятность поражения патогенными микробами многократно повышается.
- Пренебрежение личной гигиеной. Игнорирование элементарных правил, неправильное выполнение процедур увеличивают риск нарушения микрофлоры влагалища. Нужно помнить, что мыло – это щёлочь, и слишком глубокие подмывания негативно влияют на кислотно-щелочной баланс. Для женщин, девушек и девочек целесообразно использовать специальные средства для интимной гигиены. Также важно совершать манипуляции от влагалища к анальному отверстию, а не наоборот.
- Ношение белья из плотных материалов или синтетики плохо сказывается на состоянии микроклимата половых органов.
- Беспорядочная сексуальная жизнь. Незащищённый контакт с носителем патогенных микробов в 99 случаев из 100 приводит к заражению. Кроме того, если не иметь постоянного партнёра и при этом регулярно заниматься сексом, микрофлора будет неизбежно подвергаться воздействию «чужих» бактерий.
- Спринцевание. Из-за частых спринцеваний полезная флора вымывается.
- Гормональные сбои. Расстройства гормонального фона вызывают бактериальный дисбаланс.
- Ослабленный иммунитет. Когда защитные функции организма снижаются, он не может противостоять опасным возбудителям.
Сопутствующие симптомы
Тревожные признаки, связанные с нарушением микрофлоры урогенитальной сферы, в 90% случаев сложно не заметить. У женщин выделения из влагалища приобретают специфический запах (кисломолочный или рыбный), становятся обильными.

Общие для мужчин и женщин симптомы кокков в мазке:
- неприятные ощущения при мочеиспускании и близости;
- зуд и жжение разной степени выраженности;
- отёчность гениталий;
- желтоватые, белые, гнойные, кровянистые выделения из половых органов.
Женщины часто жалуются на боли внизу живота, слабость, отсутствие аппетита. Это связано с тем, что в процессе жизнедеятельности патогенные клетки продуцируют токсические вещества. Также образуются очаги воспаления, из-за которых возникает ощутимый дискомфорт.
При наличии вышеперечисленных признаков следует незамедлительно показаться гинекологу, сдать анализы и пройти полный курс терапии. К самолечению прибегать запрещено!
Осложнения
Если вовремя не обследоваться и не начать лечение, кокковые инфекции будут распространяться на соседние органы, слизистые и кожные покровы. Осложнения во многом зависят от разновидности клеток. Например, стрептококк провоцирует менингит, пневмонию, остеомиелит (поражение костных тканей).
Стафилококк вызывает эндокард (воспаление внутренней оболочки сердца), пиодермию (гнойные воспалительные процессы под кожей), пневмонию, бронхит, заболевания верхних дыхательных путей (риниты, синуситы) и пищеварительного тракта.
Кроме того, размножение патогенных бактерий во влагалище снижает выработку эстрогенов, что в результате становится причиной выкидышей и бесплодия.
Кокки в мазке при беременности осложняют процесс вынашивания ребёнка. Рост и развитие плода напрямую связаны с состоянием здоровья будущей матери, а воспалительный процесс может затрагивать не только прямую кишку и мочевыводящий канал, но и матку. Чтобы предотвратить опасность, следует планировать беременность заранее и при необходимости проводить терапию.
Наиболее распространённые последствия кокковых инфекций:
- эрозия шейки матки;
- эндометрит;
- пиелонефрит (поражение почек).
У мужчин при отсутствии адекватного лечения кокки приводят к простатиту (воспаление простаты), поражению яичек и семенных канальцев. Всё это грозит импотенцией и бесплодием.
Диагностика
Диагностика представляет собой лабораторное обследование. У женщин с задней стенки влагалища, мочеиспускательного канала и канала шейки матки делают забор мазка. Мужчинам в уретру вводят специальный зонд (если воспаление уже началось, манипуляции могут быть болезненными).
Далее образец биоматериала отправляется в лабораторию, где его окрашивают (метод Грама) и исследуют под микроскопом. В некоторых случаях может потребоваться дополнительная диагностика: мазок из зёва и носовой полости (при подозрении на стафилококк), общие анализы крови и мочи.
Перед проведением процедуры важно придерживаться следующих правил:
- не мочиться за 2 часа;
- не употреблять острую пищу и алкоголь за 3-5 дней;
- не принимать лекарственные препараты за 3-5 дней;
- воздержаться от близости за 2 дня;
- не использовать вагинальные свечи, не спринцеваться за 2 дня.
Внимание! Анализ сдают перед менструацией или спустя 4-5 суток после её окончания.
Лечение
Если обнаружено аномальное количество кокков в мазке, лечение нужно проводить в соответствии со всеми врачебными предписаниями. Настоятельно рекомендуется не использовать антибиотики общего назначения.
Как уже упоминалось, многие кокки устойчивы к таким медикаментам, поэтому терапия может оказаться не только безрезультатной, но и опасной.
Под воздействием антибактериальных средств рост патогенных клеток начнёт увеличиваться, а численность полезных бактерий – снижаться.
Для того чтобы борьба с кокками была максимально эффективной, предварительно проводится тест на чувствительность. Антибиотикограмма – бакпосев влагалища на питательную среду позволяет определить уровень восприимчивости патогенных клеток к тем или иным препаратам.
Одним из наиболее действенных препаратов против кокковых инфекций считается «Метронидазол». Его основное преимущество – отсутствие противопоказаний к применению в период беременности и кормления грудью.
Совместно с антибиотиками используют лекарства, содержащие лакто-, и бифидобактерии. Для восстановления нормальной микрофлоры применяются вагинальные свечи, мази и кремы, обладающие антисептическими свойствами. Одновременно могут быть назначены иммуномодулирующие средства.
Спринцевания травяными отварами нужно выполнять строго с разрешения гинеколога.
Внимание! Параллельно проходить лечение должен и постоянный половой партнёр. В это время лучше воздержаться от секса и мастурбации, использования тампонов.

После завершения курса терапии мазок на флору делают повторно. При отсутствии положительного результата подбирается другая группа антибиотиков. В 70-80% случаев госпитализация не требуется, лечение проводится в домашних условиях или амбулаторно.
Профилактика
Предотвратить рост и размножение кокков в организме можно посредством соблюдения элементарных правил:
- не забывать о ежедневной интимной гигиене;
- отказаться от беспорядочных половых связей (или всегда пользоваться барьерными контрацептивами);
- укреплять иммунитет, сбалансировано питаться, не пренебрегать физическими нагрузками, гулять на свежем воздухе, пить поливитаминные комплексы;
- отдавать предпочтение нижнему белью из натуральных тканей.
Сегодня благодаря современным методам диагностики опасные заболевания можно выявить ещё на начальном этапе. Это упрощает ход лечения и улучшает прогноз. Каждой половозрелой женщине рекомендуется как минимум 1-2 раза в год посещать гинеколога и делать мазок на флору. Обязательно сдавать анализы при беременности и на стадии планирования зачатия.
Важно помнить, что проще поддерживать нормальную микрофлору, чем потом избавляться от бактерий и лечить болезни, спровоцированные кокками.
Источник:
Кокки в мазке у женщин

Кокки в мазке — патология или норма?
В женском влагалище живет флора, которую в большинстве составляют палочки Дедерлейна (их второе название — ацидофильные молочные бактерии), бифидобактерии и единичные пептострептококки. Функционал такой микрофлоры заключается в создании и поддерживании умеренной кислотной среды, в которой не развиваться большинство патогенных бактерий.
Сами микроорганизмы способны уничтожать таких агентов и контролировать обменные процессы в организме. В норме мазок содержит не больше 5% полиморфных палочек. Если они повышенные в мазке, значит происходит подщелачивание содержимого влагалищной полости.
- нейтральной (pH 5,0 и ниже);
- слабокислой (pH 5 — 7);
- щелочной (pH 7,5).
Когда pH только начинает становится щелочным, появляются грамположительные диплококки и падает концентрация ацидофильных лактобактерий. По мере ощелачивания среды лактобактерии погибают и замещаются кокками. Такое явление называется влагалищным дисбактериозом, он сопровождает патологии половой и мочевыделительной систем.
Кокки в мазке — расшифровка
В мазке мазке на микрофлору может содержаться 6 видов кокков.
| Название кокка | Расшифровка |
| Стрептококк | Является условно-патогенным. Если его количество небольшое, он безопасен. Чрезмерная концентрация становится причиной влагалищного дисбактериоза и воспалительных процессов. |
| Стафилококк | Тоже условно-патогенный. Является одним из самых распространенных членов группы. Чаще всего попадает в организм человека еще на самых первых этапах его внутриутробной жизни. Если мелких стрептококков немного, женщина не страдает не от каких неприятных симптомов. Причиной активного роста микроорганизмов становятся патологии мочевыделительной системы. Для подтверждения диагноза сдается мазок из носа и зева. |
| Диплококки (парные) | Этого кокка в мазке в норме не должно содержаться. Он негативно влияет на микрофлору влагалища и может стать причиной пневмококковой или менингококковой инфекции. |
| Энтерококк | Стандартный представитель микрофлоры кишечника. Он не является патогенным, но в норме этого кокка быть не должно. Его содержание в мазке чаще всего указывает на пренебрежение правилами интимной гигиены. |
| Коккобациллы | В группу входят: хламидия, гемофильная палочка и гарденерелла. Такие кокки в мазке у женщин указывают на наличие указывают на наличие ЗППП у пациента или влагалищный бактериальный вагиноз (диагноз подтверждается дополнительным анализом мочи и крови). |
| Гонококк | Означают наличие заболеваний мочевыводящих путей. Они вызывают воспалительные процессы в данных органах и могут стать причинами сальпингита и цервицита. |
Большинство болезней, которые вызваны кокками, имеют склонность прогрессировать. Если патология сопровождается воспалительным процессом, он может перекинуться и на близлежащие органы.

Кокковая инфекция может быть чревата эндометритом, эрозией шейки матки и, в крайних случаях, бесплодием.
Причины появления кокков
Существует множество причин появления кокков в мазке у женщин.
- Неправильная или скудная гигиена. Многие женщины неправильно омывают влагалище, это может быть причиной нарушения чистоты. Подмывание нужно делать по направлению к анальному отверстию, а не наоборот. При процедурах рекомендуется использовать неагрессивные средства с правильным pH балансом (мыло прочь!).
- Наличие беспорядочных половых связей. Случайные партнеры могут быть источником разный инфекций, не только кокковых. Лучше практиковать сексуальные акты только с проверенным партнером. Если это невозможно, следует обязательно предохраняться.
- Гормональный дисбаланс.
- Нетрадиционный секс с зараженным человеком. Многие считают, что заразиться можно только посредством вагинального секса, но это не так. Через анальный или оральный половой акт заразиться достаточно просто, ведь большая часть людей при такой практике не предохраняются.
- Мастурбация грязными предметами или руками.
- Женщина слишком рано начала половую жизнь. До момента полноценного полового созревания микрофлора еще не успевает до конца сформироваться и может быть не подготовленной к сексуальному контакту.
- Длительное лечение антибиотиками, которое не согласовывалось со специалистом. Такие препараты способны вычищать не только отрицательную, а и положительную флору. Женщины, которые любят заниматься самолечением, не задумываются о том, что нужно параллельно восстанавливать её специальными средствами. В результате неправильной терапии флора становится уязвимой для инфекций.
- Частые спринцевания, в особенности проводимые дома.
Часто на фоне поражения различными кокками состояние влагалищной флоры ухудшается из-за попадания в неё и других сторонних организмов. Это связано с тем, что флора стала беззащитной и потеряла свою барьерную функцию.
Лечебные мероприятия
Терапию начинают, если при анализе была выставлена 3 или 4 степени чистоты. При третей степени кокковая флора преобладает над остальной и присутствует обильно разбросанные лейкоцитарные клетки.
При четвертой степени чистоты лейкоцитов еще больше, есть много посторонних кокков, а ацидофильных лактобактерий нет вообще.
При 3 и 4 степенях у женщины уже появляются такие неприятные симптомы, как зуд половых губ и влагалища, выделения со зловонным запахом, необычной консистенцией и цветом.
Лечение в обязательном порядке должны проходить оба партнера (если второй из них постоянный), иначе повторного заражения не избежать.
Народными средствами лечить кокковые инфекции нельзя. Терапия проводится серьезными медикаментозными препаратами. Для того, чтобы подобрать эффективный препарат, предварительно делается бактериологический посев.
Для лечения пациенткам обычно назначают сразу несколько лекарств.
- Антибиотики. Могут быть локальными или системными. В качестве системных используются средства в форме уколов или таблеток, локальных — влагалищные таблетки или свечи. Самым часто назначаемым препаратом является Метронидазол (он же Клиол, Трихопол, Флагил). Его выписывают небеременным женщинам. Данное лекарство эффективно против большей части грибков, простейших и кокков. Курс лечения в среднем длится 7-10 дней. Если у женщины присутствует аллергия, Метронидазол можно заменить Тинидазолом или Клиндамицином. При лучше всего подходят Хлоргексидин (Гексикон) — это местный антисептик, или Тержинан — средство в форме таблеток с широким вектором действия.При обнаружении генококка для лечения используются другие средства. Они принимаются единоразово. Женщине могут назначить препараты на основе офлоксацина, ципрофлоксацина или цефиксима.
- Иммуномодуляторы и препараты против вагинального дисбактериоза с лактобактериями в составе. Они нужны для укрепления иммунитета и восстановления микрофлоры. Препараты пьются одновременно с антибиотиками. Подбираются они в индивидуальной форме.
- Общие и местные антисептики (по необходимости).
При лечении инфекции женщина обязательно должна придерживаться установленного ритма лечения и не забывать о приеме препаратов конкретное количество раз и в определенное время. Пренебрежение этим нюансом может свести эффективность лечения на «нет».
Что еще нужно знать при лечении инфекции?
Помимо основного медикаментозного лечения существует ряд профилактических мер, которые обязательны к выполнению при проведении терапии.
- Менять белье ежедневно. Грязные трусы являются благоприятной средой для развития вредной микрофлоры, поэтому за их частотой нужно следить постоянно. Правило действует не только во время лечения. Для носки лучше всего подходит белье из натуральных тканей, синтетику носить нельзя. После стирки их желательно обдавать горячим паром для дополнительной дезинфекции.
- Укреплять иммунитет. В этом деле поможет сбалансированный рацион, витамины и спорт.
- Не практиковать спринцевания (во время терапии вообще полностью исключить). Эта процедура может сильно нарушить микрофлору.
- Не использовать ежедневные прокладки. В гигиенических целях лучше чаще проводить подмывания со средствами с нейтральным pH или просто водой.
- Постараться свести к минимуму половые акты. Если они случаются, нужно обязательно использовать презерватив.
- Регулярно мониторить течение лечения с помощью анализов и предоставлять их результаты лечащему врачу.
Все эти нюансы могут повлиять на результативность лечения. Женщинам, которые прошли терапию до конца, следует сдать повторный мазок на флору где-то через месяц после этого.
Пожалуйста оцените статью,
мы старались:
Источник:
Кокковая флора в мазке у женщин: причины, симптомы и лечение

16.01.2018
23.1 тыс.
15.5 тыс.
6 мин.

Время чтения: 6 мин.
Микрофлора влагалища здоровой женщины представлена различными видами бактерий: полезными и условно-патогенными. В норме они находятся в определенном соотношении.
Если по какой-либо причине этот баланс нарушается, риск развития мочеполовых инфекций у женщины возрастает. Обильная кокковая флора часто наблюдается в результатах гинекологического мазка именно при таком дисбалансе.
Золотым стандартом диагностики в гинекологии является исследование мазка, взятого из заднего свода влагалища и цервикального канала. В норме могут быть обнаружены:
- 1Ацидофильные палочки Додерляйна (лактобактерии). В норме их количество должно составлять не менее 85-95% от всей флоры или 106-108 копий в образце.
- 2Бифидобактерии (около 10%).
- 3Пептострептококки, эубактерии, превотеллы, бактероиды, фузобактерии и другие анаэробные бактерии (5%).
- 4Другие кокки и грибы (в малом количестве).
- 5Эпителий (немного, его количество зависит от фазы менструального цикла).
- 6Лейкоциты (до 10 клеток).
Такое соотношение микроорганизмов способно длительно поддерживать слабокислую среду, позволяет бороться с патогенными бактериями, обеспечивает естественное увлажнение и местный иммунитет. Состояние микрофлоры влагалища оценивается с помощью лабораторных методов и имеет свою условную классификацию.
2. Степени чистоты влагалища
Понятие о степенях чистоты было введено для того, чтобы своевременно выявить женщин из группы риска по воспалительным заболеваниям половых органов (вагинит, цервицит, эндометрит и так далее). Об этом подробнее можно прочитать в другой нашей статье (перейдите по внутренней ссылке). Их выделяют на основании результатов простого мазка на флору и GN:
- 1Первая степень (второе название — нормоценоз): кислая среда. Нормальное количество лактобактерий, немного клеток эпителия, кокки отсутствуют. Встречается редко, как правило, наблюдается сразу после лечения, применения антибиотиков.
- 2Вторая степень: кислая среда. Число лактобактерий несколько снижено, появляются лейкоциты (до 10) и мелкие диплококки. Количество кокков незначительное (один или два плюса).
- 3Третья степень: среда становится слабокислой или щелочной. Количество палочек Додерляйна значительно ниже нормы, много эпителия, лейкоциты 10-30, кокковая или бациллярная флора преобладает, может обнаруживаться мицелий грибков. Это состояние и называют дисбиозом (дисбактериозом). Таким женщинам необходимо наблюдаться и вовремя получать лечение.
- 4Четвёртая степень: щелочная среда. Лактобациллы могут вовсе отсутствовать, большое количество клеток эпителия, лейкоцитов (выше нормы), много кокков или других патогенных бактерий. Эта степень соответствует вагиниту, следовательно, лечение женщины обязательно.
По мере сдвига pH в щелочную сторону меняется качество и количество флоры. Постепенно уменьшается уровень ацидофильных палочек, размножаются кокки, затем присоединяются грибы и другие бактерии.
Щелочная среда губительна для палочек Додерляйна, что приводит к развитию дисбактериоза влагалища.
Стоит отметить, что в нормальных мазках могут встречаться следующие микроорганизмы: гемолитический стрептококк, золотистый, эпидермальный и сапрофитный стафилококк, пептококки, микрококки, зелёный стрептококк и другие. Все они в небольшом количестве не представляют угрозы для здоровья и являются условно-патогенными представителями влагалищной флоры.
При 3-4 степени чистоты влагалища чаще всего можно обнаружить следующие виды кокков:
- 1Стрептококки. Как уже говорилось выше, эти микроорганизмы допускаются в небольшом количестве, но усиленное их размножение приводит к возникновению воспалительного процесса — вагиниту.
- 2Энтерококк фекальный. Часто встречается в кишечнике, при попадании в мочеполовые пути способен вызывать цистит или кольпит. Обнаружение его в мазках в большом количестве говорит о нарушении правил интимной гигиены, в том числе и во время секса.
- 3Стафилококк – условно-патогенный микроорганизм, в норме обитающий на коже. При усиленном его размножении способен вызвать серьёзное воспаление с поражением наружных и внутренних половых органов.
- 4Диплококк встречается при дисбиозе влагалища с нарушением нормального состава микрофлоры слизистой.
Существуют и другие кокки, они обычно вызывают неспецифические кольпиты.
Важно! Если в гинекологическом мазке выявлен золотистый стафилококк, то есть вероятность его обнаружения и на слизистых верхних дыхательных путей (ротоглотка, полость носа).
3. Причины появления кокков в гинекологическом мазке
Кокковая флора в мазке у женщин может наблюдаться по нескольким причинам:
- Несоблюдение женщиной правил личной гигиены. Сюда можно отнести неправильный и нерегулярный уход за половыми органами, редкая смена нижнего белья, постоянное использование ежедневных прокладок, применение щелочного мыла.
- Длительное бесконтрольное употребление антибиотиков.
- Частая смена половых партнёров, отказ от барьерных методов контрацепции, неправильное чередование анального, орального и вагинального секса в пределах одного полового акта, несоблюдение правил гигиены секса.
- Злоупотребление спринцеваниями, особенно с антисептиками (вымывание нормальной микрофлоры).
- Начало сексуальной жизни до 15 лет, отсутствие грамотности в плане интимной гигиены.
- Гормональные изменения у женщин в период менопаузы, при беременности, нарушениях менструального цикла.
- Общие соматические заболевания, хронические инфекции, прием глюкокортикоидов, которые ослабляют иммунитет.
- Механическое повреждение слизистой оболочки (нарушение естественной барьерной функции).
4. Какие симптомы могут наблюдаться?
Активное размножение кокковой флоры рано или поздно приведёт к появлению клинических симптомов заболевания. Признаки воспалительного процесса во влагалище неспецифичны, то есть по ним нельзя определить, какие именно кокки размножаются в половых путях.

Изменение состава микрофлоры женщина может заподозрить по следующим симптомам:
Симптомы кольпита достаточно яркие, не заметить их невозможно. Если игнорировать признаки заболевания, то инфекция может привести к следующим осложнениям:
- 1Неспецифический цервицит (воспаление слизистой оболочки шейки матки).
- 2Эндометрит, сальпингоофорит (появляются при снижении местного или общего иммунитета).
- 3Цистит, пиелонефрит часто развиваются на фоне вульвовагинита, имеют хроническое течение с частыми рецидивами. Они связаны с половым актом, при котором происходит занос флоры из половых путей в уретру.
- 4Присоединение патогенной флоры (трихомонады, грибы Кандида, хламидии). Нарушение микрофлоры способствует заражению ИППП при наличии инфицированного полового партнера.
- 5Осложнения нормальной беременности.
5. Мазки во время беременности
В последнее время число воспалительных заболеваний и дисбиоза половых органов у беременных женщин увеличивается.
Это может быть связано с бесконтрольным приемом некоторых антибиотиков, гормонов (контрацепция перед планированием или для лечения бесплодия), неправильным питанием, образом жизни, снижением иммунитета. Появление кокковой флоры в мазках у беременных резко повышает вероятность присоединения патогенной флоры, чему способствуют:
- Изменение гормонального фона.
- Ослабление местного иммунитета на фоне вынашивания ребёнка.
Кроме того, многие препараты не рекомендованы для лечения беременных женщин, поэтому при появлении избыточной коккобациллярной микрофлоры возможности терапии значительно снижаются.
Активное размножение условно-патогенных бактерий влечёт за собой развитие воспаления слизистой влагалища, шейки матки, мочевого пузыря. Опасность их заключается в повышении риска внутриутробной инфекции с задержкой развития плода, невынашивания и других осложнений.
6. Методы диагностики
Выявление кокков во влагалище у женщин возможно с помощью трех лабораторных анализов: простого мазка на флору, теста «Фемофлор» в модификации Фемофлор 8 (10) или Фемофлор 16 (17) и бакпосева.
Чаще всего у женщин используется простой мазок. Забор материала для исследования проводится из 2 или 3 точек: слизистая заднего свода влагалища, шейки матки и иногда уретры.
Перед взятием материала не следует спринцеваться, применять свечи с антисептиками, принимать антибиотики, заниматься сексом, так как результат будет искажён.
Биоматериал наносится на стерильные стёкла и изучается под микроскопом. При необходимости делается посев на питательные среды с определением чувствительности к антибиотикам.
Иногда исследования лишь мазков на флору бывает недостаточно для постановки диагноза, поэтому прибегают к дополнительным обследованиям (Фемофлор, ПЦР в режиме реального времени, УЗИ, PAP-тест, кольпоскопия и др.).
7. Препараты для лечения
Лечение зависит от характера выявленной микрофлоры, симптомов заболевания и общего состояния женщины. При обнаружении большого количества кокков и лейкоцитов в мазке показана местная терапия в виде вагинальных свечей, овулей и капсул:
- 1Гексикон (хлоргексидин в виде свечей).
- 2Флуомизин (деквалиния хлорид).
- 3Тержинан, Полижинакс.
- 4Клиндамицин.
- 5Макмирор (нифурантел).
- 6Нео-Пенотран.
- 7Бетадин (сейчас используется все реже, часто вызывает неприятные ощущения, зуд, жжение).
- 8Местные антисептики в растворах — Мирамистин, Хлоргексидин.
При тяжелом воспалительном процессе назначаются системные антибиотики: цефтриаксон, цефиксим, амоксиклав и др.
Дополнительно могут быть назначены средства для восстановления нормальной вагинальной микрофлоры. Полноценных исследований по их применению не проводилось, однако этот вопрос активно изучается. Пробиотики не показаны при молочнице, так как могут спровоцировать ее рецидив.
Местные пробиотики в виде вагинальных свечей или таблеток:
- 1Вагинорм-С с аскорбиновой кислотой закисляет среду влагалища и нормализует состав микрофлоры, используют по 1 таблетке вагинально перед сном 6 дней.
- 2Ацилакт с живыми ацидофильными бактериями по 1 свече 2 раза за день 7-10 дней.
- 3Лактонорм по 1 вагинальной капсуле 2 раза в день 7 дней.
После лечения повторно берутся мазки для контроля эффективности терапии. При отсутствии эффекта назначаются альтернативные схемы или продлевается основной курс антибиотиков в виде вагинальных форм.

Лечиться можно амбулаторно, в домашних условиях. Из народных средств могут быть рекомендованы сидячие ванночки с ромашкой, календулой, раствором фурацилина.
8. Профилактика
Для предупреждения нарушений баланса микрофлоры половых путей нужно по возможности устранить все провоцирующие факторы:
- Устранить гормональный дисбаланс (ЗГТ при климаксе, оральные контрацептивы по показаниям).
- Соблюдать ежедневную интимную гигиену, а также во время менструации и секса. Отказаться от спринцеваний без назначения врача.
- Использовать презервативы.
- Вести здоровый образ жизни, быть активной, заниматься спортом или лечебной гимнастикой, правильно питаться, избегать частого употребления антибиотиков, беречь свой организм от инфекций.
- Одним из способов профилактики также является регулярное посещение гинеколога и лечение хронических заболеваний не только половой системы, но и других органов.
- 1Vaginal Dysbiosis from an Evolutionary Perspective. Natalia Schlabritz-Loutsevitch, Scott E Gygax,Edward Dick, Jr., William L. Smith, Cathy Snider, Gene Hubbard, and Gary Ventolini. Sci Rep. 2016; 6: 26817.
- 2The laboratory diagnosis of bacterial vaginosis. Deborah Money, MD FRCSC. Can J Infect Dis Med Microbiol. 2005 Mar-Apr; 16(2): 77–79.
- 3Гинекология.
Национальное руководство / Под ред. Кулакова В.И. и др. – М., 2009 год – 1088 с.
- 4Гинекология / под редакцией В.Е.Радзинского, А.М.Фукса. ̶ М.: ГЭОТАР-Медиа, 2014. ̶ 1000 с.
- 5The Changing Landscape of the Vaginal Microbiome / Bernice Huang, Jennifer M. Fettweis, J. Paul Brooks et al. // Clin Lab Med. ̶ 2014 December ; 34(4): 747–761. doi:10.1016/j.cll.2014.08.006.
- 6
Источник:
Обнаружены кокки в мазке: что это такое?

Обнаружив в листе анализов запись «кокки в мазке», хочется понять насколько это опасно для здоровья.
Наличие подобных микроорганизмов в микрофлоре мочеполовых органов человека не всегда сигнализирует о каких-либо проблемах со здоровьем. Однако количество бактерий не должно превышать определенное значение.
В противном случае активная деятельность кокковой инфекции может привести к неприятным последствиям.
Природа бактерии
В организме человека постоянно присутствует огромное множество различных бактерий, микробов и прочих микроорганизмов. Подобный симбиоз между человеком и бактерией вполне оправдан.
Микрофлора мочеполовых органов человека лишь в том случае будет нормальной и здоровой, если в ней будет поддерживаться особая кислая среда, которую создают условно-патогенные бактерии.
Условность их болезнетворности подтверждается полезными функциями, которые бактерии выполняют в организме человека, а именно:
- поддерживают определенный уровень кислотности микрофлоры;
- улучшают обменные процессы;
- уничтожают другие болезнетворные палочки, бактерии и микробы.
Среди всех бактерий, населяющих флору мочеполовой системы человека, в отдельную группу выделяют мелкие одноклеточные бактерии — кокки. Эти микроорганизмы имеют почти идеальную сферическую форму. Эти кокковые шарики после деления клетки складываются в различные структуры, что и определяет их тип:
- стрептококки — факультативно-анаэробные бактерии, сложенные в форме цепочки;
- диплококки — сложенные парами кокковые палочки;
- тетракокки — структура клетки состоит из 4 бактерий;
- сарцины — имеют форму куба, образованную из 8 клеток и более;
- стафилококки — хаотично сложенные клетки.
Не все бактерии семейства Streptococcaceae имеют патогенную природу. Так, сарцины не обладают болезнетворностью и способностью к спорообразованию, практически неподвижны. Кокки сарцины встречаются в воде, воздухе, а также населяют микрофлору человека, обитая на коже и в толстом кишечнике.

В то же время другие представители кокковой природы могут представлять опасность для здоровья человека. Заболевания, вызванные инфекцией Streptococcus spp. (стрептококковыми бактериями), могут поражать дыхательные пути, сердечно-сосудистую и мочеполовую системы человека, и пр.
Стафилококки и диплококки при активном размножении инфицируют кишечник, мозг, вызывают венерические заболевания.
Кокковая инфекция отличается высокой устойчивостью к антибиотикам и высоким температурам.
Кокки в мазке
Обнаружить присутствие грамположительных кокков в микрофлоре можно как у женщины, так и мужчины.
Микрофлора влагалища у женщин содержит большое количество микроорганизмов:
- лактобактерии;
- бифидумбактерии;
- пептострептококки.
Коккобациллярная флора в мазке
Большинство микроорганизмов составляют лакто- и бифидумбактериальную среду. Именно деятельность этих микроорганизмов поддерживает неблагоприятную для размножения патогенных микроорганизмов среду в мочеполовой системе женщин.
Кокковая флора, состоящая из грамположительных пептострептококков, составляет порядка 5% и не является патологией. Если же количество кокков превышает 5%-ный порог, начинается дисбактериоз.
Такая реакция организма вызывается щелочной средой микрофлоры, которая убивает полезные и активизирует патогенные бактерии.
Наличие бактерий стрептококка в мазке у мужчин тоже не является опасным. Как и у женщин, микрофлора половых органов представителя сильного пола содержит значительное количество микроорганизмов патогенного и условно-патогенного характера. Оптимальный баланс этих бактерий обеспечивает нормальную работу мочеполовых органов мужчины.
Причины наличия кокков в мазке
Нарушение микрофлоры влагалища у женщин или уретры у мужчин может быть вызвано многими причинами. Коккобациллярная флора в мазке появляется:
- При длительном и интенсивном приеме антибиотиков. Особенно если употребление лекарств происходило без консультации и контроля врача.
- Из-за несоблюдения личной гигиены, особенно внешних репродуктивных органов.
- При незащищенном половом акте с инфицированным партнером.
- При использовании грязных рук (предметов) для мастурбации.
- Из-за частой смены половых партнеров.
- При наличии других хронических заболеваний (дисбактериозе кишечника, диабете и пр.).
- При частых стрессах, снижающих иммунитет человека.
Причинами дисбаланса микрофлоры интимных органов может стать ношение синтетического белья или слишком узкой одежды. Употребление в пищу сладких высокоуглеводистых продуктов повышает риск возникновения коккобациллярной среды в уретре.
Несоблюдение личной гигиены
У девочек, не достигших полового созревания, нарушение микрофлоры влагалища — явление нередкое. Происходящие гормональные перестройки в организме и незрелость репродуктивной функции повышают чувствительность слизистых оболочек половых органов девочки, что создает предпосылку к возникновению кокковой инфекции.
Симптоматика кокковых заболеваний
Проявление кокковой инфекции мало чем отличается от симптоматики обычных венерических заболеваний. При этом сами кокки не относятся к инфекционным микроорганизмам. Среди основных признаков развития коккового заболевания отмечают:
- сильный зуд и жжение в области уретры;
- покраснение и отек слизистой влагалища;
- сухость слизистой;
- неприятный запах из вагины;
- густые обильные выделения;
- болезненные мочеиспускания;
- тянущая боль внизу живота;
- болевые ощущения при половом акте.
Выделения часто имеют желтый или зеленоватый цвет. Их запах может напоминать испорченную рыбу. Женщина может чувствовать ухудшение общего состояния. В некоторых случаях наблюдается повышение температуры тела.
Сильный зуд и жжение в области уретры
Симптоматика кокковой активности в микрофлоре у мужчин такая же, как у женщин. Если при мочеиспускании мужчина чувствует боль, которая проходит через некоторое время, то скорее всего коккобацилярная инфекция уже попала в уретру.
Как правило, такие болевые ощущения сопровождаются частыми позывами в туалет. Болевые симптомы могут наблюдаться при половой активности. Одним из признаков наличия патогенной палочки в микрофлоре уретры является воспаление головки полового члена, из которой может выделяться гной.
При выделении гнойных жидкостей мужчина может испытывать ноющую боль.
Симптомы, указывающие на развитие патологии, могут встречаться по отдельности или в совокупности. Известны случаи бессимптомного протекания заболевания. Именно поэтому необходимо регулярно проходить консультацию медицинских специалистов и сдавать соответствующие анализы.
Диагностика и лечение кокковых инфекций
При обнаружении каких-либо симптомов заболевания женщине или мужчине необходимо сразу же обратиться к врачу. Если подобные симптомы были обнаружены только у одного партнера, второму также необходимо проконсультироваться с врачом. Совместное лечение поможет избежать риска повторного заражения.

Обычно диагностика мочеполовых заболеваний, вызванных палочками кокки, начинается с осмотра специалистом и сдачи анализов. У пациента, помимо мазка, берут на анализы кровь и мочу. Рекомендуется провести тест на чувствительность организма к некоторым препаратам.
Диагностика мочеполовых болезней
После установления типа кокка и стадии поражения микрофлоры уретры врач подбирает терапию.
Для лечения коккобацилярных заболеваний используют:
- антибактериальные препараты, например: Метронидазол, Флуконазол, Тинидазол;
- иммуностимулирующие средства;
- антисептические препараты.
Для санации внешних половых органов врачи рекомендуют народные средства в виде отвара ромашки или календулы. Для этой цели назначаются и медикаментозные препараты, например, Панавир, Макримор, Мирамистин.
Для большей эффективности лечения используются ректальные или вагинальные свечи, к примеру Гексикон или Полижинакс.
Для снятия некоторых неприятных симптомов врач может порекомендовать прием антигистаминных препаратов.
Для лечения кокковой инфекции у мужчин врач прописывает препараты местного применения: мази Левомеколь, Батрафен или Клотримазол. Эти средства обладают противовоспалительными и антисептическими свойствами. Особенно хорошо подобные мази справляются с воспалениями, вызванными бактериями Streptococcus spp.
Если воспалительные процессы имеют запущенную форму, то медики прибегают к использованию антибиотиков. Чаще всего при обнаружении стрептококка в мазке у мужчин и диагностировании тяжелых воспалительных процессов назначают Биомицин, Тетрациклин.
Мазь Левомеколь
Врачи не рекомендуют заниматься самодиагностикой и самолечением. Грамотная терапия определяется только специалистом с учетом особенностей организма пациента, вида кокковой палочки и стадии заражения. Любое пренебрежение лечением может привести к распространению инфекции.
У женщин активность кокковых бактерий может привести к эндометриозу и эрозии шейки матки. У мужчин отсутствие терапии чревато воспалением предстательной железы. При переходе заболевания в хроническую форму возрастает риск поражения детородных органов и развития бесплодия.